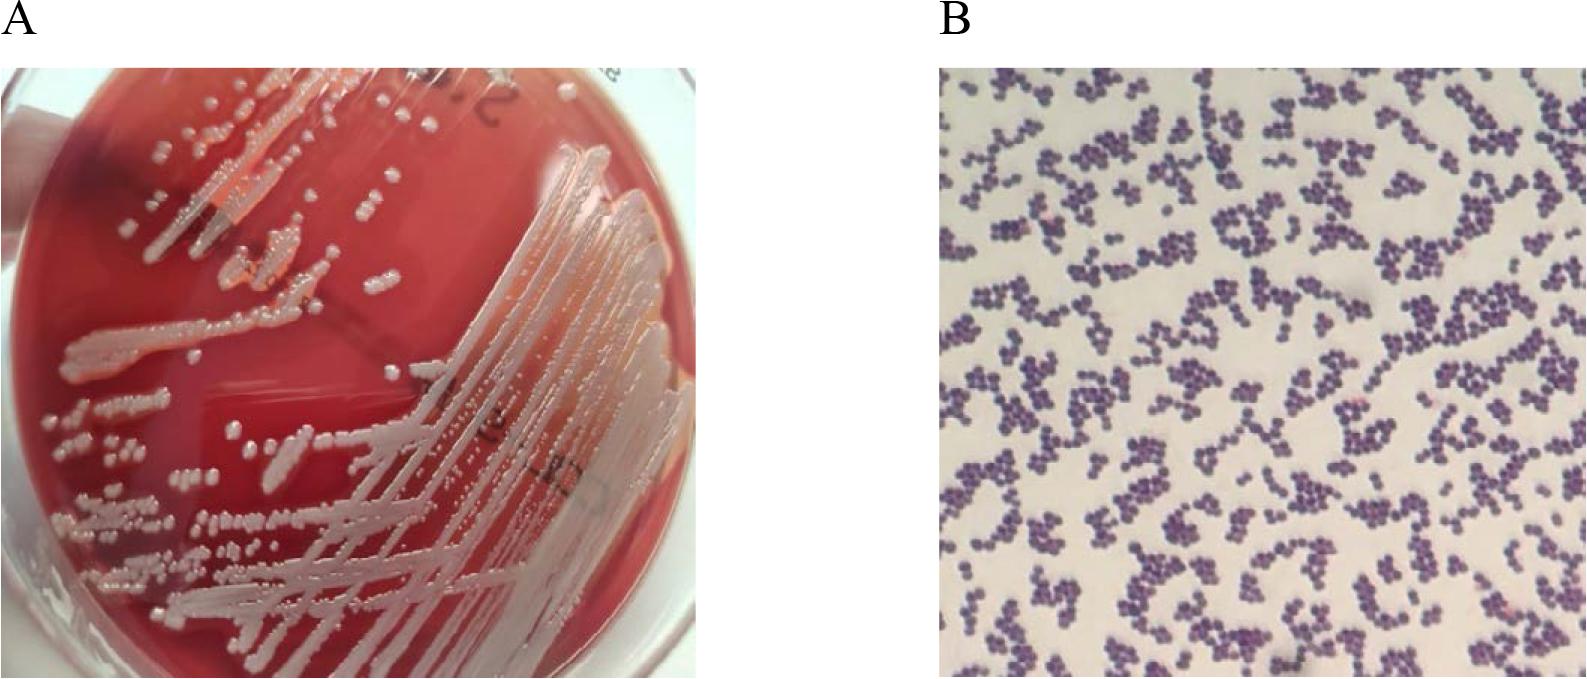
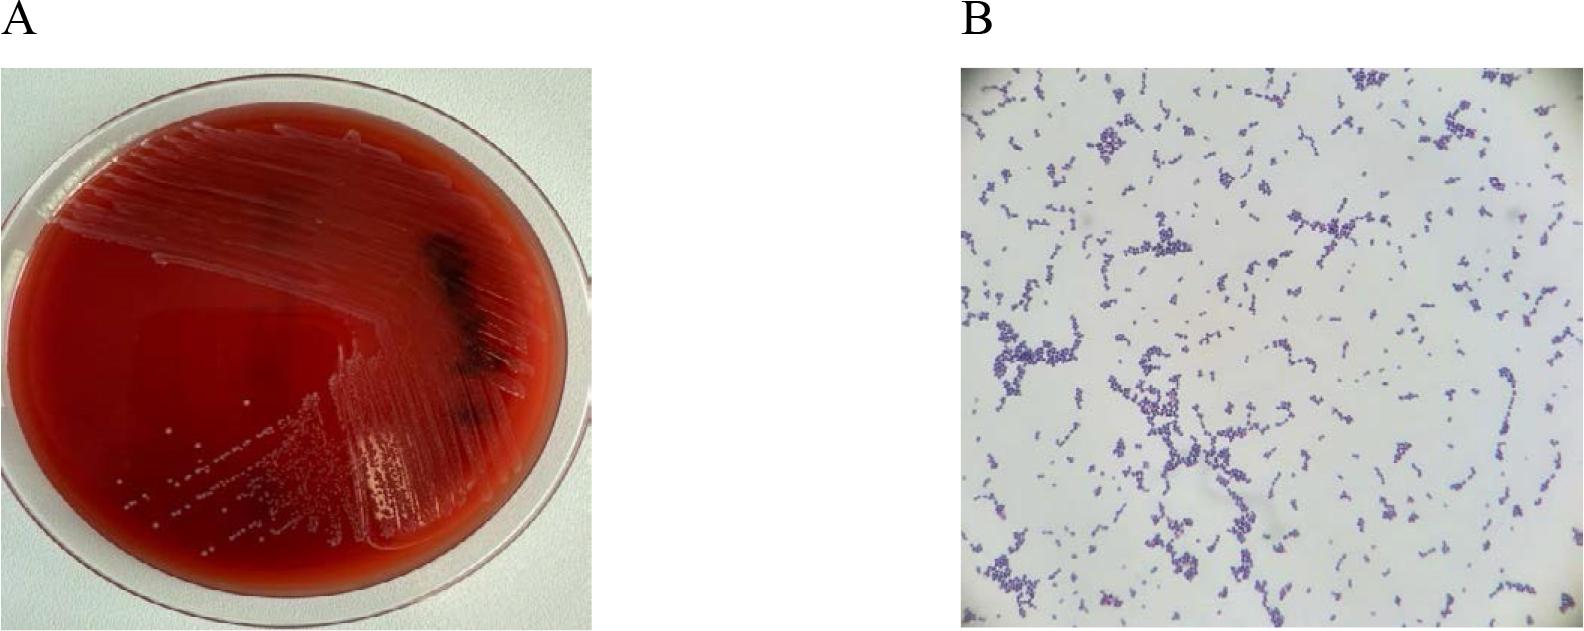
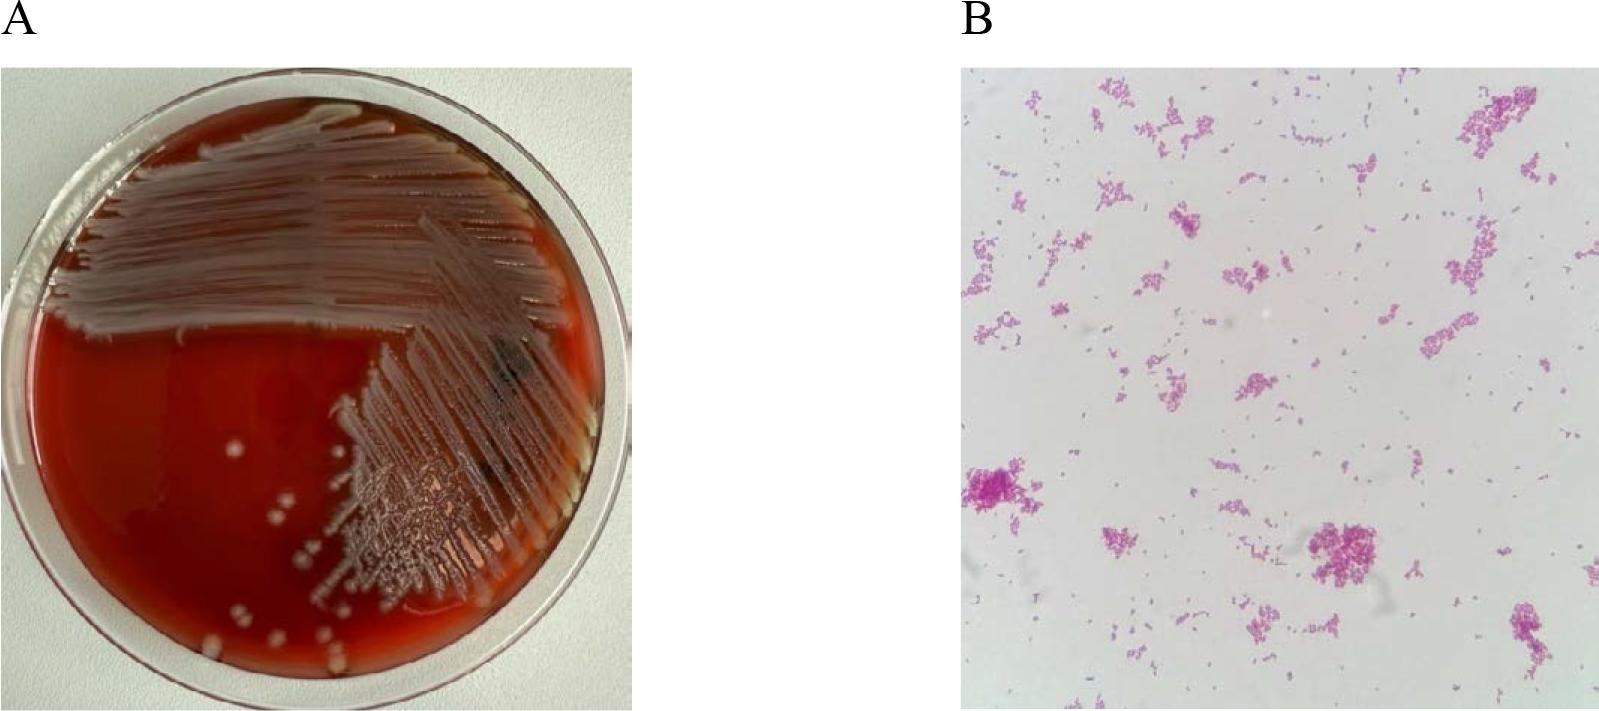

A healthcare-associated infection is defined as an infection that occurs during a patient’s hospitalization but was not in the incubation period at the time of admission to the hospital [38]. In recent years, the issue of healthcare-associated infections has become a significant topic of discussion in both medical and non-medical environments. Effective infection control requires extensive knowledge in microbiology, epidemiology, and economics. It is generally accepted that the level of infection control is an important indicator of the quality of medical care. Properly conducted surveillance not only helps to reduce morbidity and mortality among hospitalized patients but also significantly reduces treatment costs [1].
Continuous monitoring of the epidemiological situation in healthcare facilities enables the early detection of healthcare-associated infections and effective preventive actions. Key elements include supervision of adherence to medical and hygiene procedures, rapid identification and reporting of microbial resistance mechanisms, and the rational use of antibiotic therapy. The main factors contributing to the development of hospital infections include prolonged hospitalization, previous antibiotic therapy, mechanical ventilation, as well as the use of vascular and urinary catheters [1, 49]. Despite advances in medicine and the development of modern pharmacotherapy, healthcare-associated infections remain a significant issue in closed healthcare settings. They are closely linked to complications arising from medical or nursing procedures [32]. These infections are often caused by strains that colonize the hospital environment. Numerous studies indicate that a contaminated hospital environment is responsible for the transmission of multidrug-resistant organisms (MDROs), including mycobacteria, viruses, and fungi. Hospitalized patients are the primary source of pathogenic microorganisms that can be present in the hospital environment. These microorganisms are capable of surviving for extended periods on surfaces, in water, and in the air, colonizing or contributing to the development of difficult-to-treat bacterial infections [34]. The growing phenomenon of bacterial resistance to antibiotics is one of the greatest challenges in modern medicine. According to the predictions of the World Health Organization (WHO), if the rate of antibiotic resistance continues at its current pace, infections caused by resistant bacterial strains will become the leading cause of death worldwide in the future, surpassing cancer, diabetes, and cardiovascular diseases [31].
Antibiotic resistance in bacterial strains is a global issue that affects all countries around the world. This phenomenon is considered one of the greatest challenges in modern medicine, significantly impacting the effectiveness of infection treatment. Antimicrobial resistance refers to the ability of microorganisms to adapt and grow despite the presence of substances that have bactericidal and bacteriostatic effects [13]. Bacteria have developed a range of defense mechanisms that enable them to neutralize the action of antibiotics. At the same time, the antibiotics used in therapy differ in their mechanisms of action, including inhibiting cell wall synthesis, damaging the protoplasmic membrane, and blocking the biosynthesis of proteins or nucleic acids (Fig. 1) [9, 42].

Mechanisms of Antibiotic Action.
The development of bacterial resistance to antibiotics is attributed to changes at the genetic material level, which can be located both in the bacterial chromosome and on extrachromosomal elements. Two main types of resistance are distinguished: natural and acquired.
Natural resistance is a species-specific trait resulting from the structure of the bacterial cell, limited antibiotic transport into the cell, low affinity of the drug to its molecular target, or the activity of enzymes that degrade antibiotics. This mechanism is chromosomally encoded.
Acquired resistance develops as a result of spontaneous mutations in the chromosomal DNA or through horizontal gene transfer of resistance genes located on plasmids, transposons, integrons, or insertion sequences. These processes occur during conjugation, transduction, or transformation, which facilitates the rapid spread of resistance [9, 14, 36].
In the case of acquired chromosomal resistance, a single-step mutation is sufficient, although in clinically significant microorganisms, multi-step mutations or mutations in one or more genes simultaneously are more common. Examples of acquired chromosomal resistance include:
Methicillin resistance in Staphylococcus
Beta-lactam antibiotic resistance in Streptococcus pneumoniae
Rifampicin resistance in tuberculosis mycobacteria
Resistance associated with changes in permeability – porin channels – in Gram-negative rods
Resistance associated with active expulsion of antibiotics from the cell – efflux pumps – in Gram-negative rods
Quinolone resistance related to mutations in the gyrase and topoisomerase genes
Production of AmpC cephalosporinases [9].
Plasmid-mediated resistance results from the presence of mobile genetic elements in the bacterial cell, containing genes responsible for antibiotic resistance. These include plasmids, transposons, integrons, and insertion sequences. The exchange of these elements can occur both within species and between species, significantly increasing the scale of resistance spread (Fig. 2.) [2, 37].

Gene transfer of resistance in the conjugation process involving fimbriae.
Multidrug resistance in bacteria often arises from two main mechanisms. The first involves the accumulation of multiple resistance genes, each conferring resistance to a different antibiotic. These genes are most commonly located on resistance plasmids (R) or transposons. The second mechanism is associated with increased expression of genes encoding efflux pumps, which actively expel drugs from the bacterial cytoplasm to the outside. Importantly, a single multidrug efflux pump can remove more than one type of antibiotic from the cell [4].
One of the most important groups of drugs used in the treatment of bacterial infections are β-lactam antibiotics. Unfortunately, many microorganisms exhibit resistance to this group of compounds by producing β-lactamase enzymes, which inactivate the antibiotic by hydrolyzing the β-lactam ring, usually in the periplasmic space [9, 42].
According to Ambler’s classification, based on amino acid sequence homology, β-lactamases are divided into four classes (A, B, C, D) (Tab. 1). These enzymes are encoded by genes such as bla, found in both Gram-positive and Gram-negative bacteria. β-lactamases break down penicillins, cephalosporins, carbapenems, and monobactams. Among them, penicillinases, cephalosporinases, and enzymes with broad substrate specificity are distinguished. Individual β-lactamases differ in sensitivity to inhibitors such as clavulanic acid, sulbactam, or tazobactam, whose primary role is to protect the antibiotic from enzymatic degradation [16, 19, 36].
Classification of β-lactamases according to Ambler.
| Class | Active site | Type of β-lactamases | Substrates |
|---|---|---|---|
| A | Serine | Penicillinases | Penicillins, first-generation cephalosporins |
| ESBL | Penicillins, first, second, third, and fourth-generation cephalosporins, aztreonam | ||
| Carbapenemases | Penicillins, first, second, third, and fourth-generation cephalosporins, carbapenems, monobactams | ||
| B | Zn++ | Metallo-β-lactamases | β-lactams except monobactams |
| C | Serine | AmpC cephalosporinases | Penicillins, cephalosporins (except for fourth-generation cephalosporins and carbapenems) |
| D | Serine | Oxacillinases | Penicillins (including isoxazolyl penicillins), first and second-generation cephalosporins |
| Carbapenemases | Carbapenems |
Genes responsible for resistance to β-lactam antibiotics can be found both on plasmids and within the bacterial chromosome. An example includes penicillinases found in Gram-positive bacteria, such as penicillin – and ampicillin-resistant staphylococci [16, 19, 36].
Cephalosporinases can be encoded both chromosomally and plasmidically. The chromosomal AmpC cephalosporinase hydrolyzes penicillins, cephalosporins (except for the fourth generation), and aztreonam, and it is not sensitive to β-lactamase inhibitors. Plasmid-mediated cephalosporinase (pAmpC) arises from the translocation of the ampC gene onto a plasmid or another mobile genetic element. Microorganisms possessing pAmpC pose a significant epidemiological threat due to the ease with which the resistance gene can be transferred between bacteria.
Broad-spectrum substrate enzymes found on plasmids include classical β-lactamases (TEM, SHV), extended-spectrum β-lactamases (ESBLs), and carbapenemases. Unlike AmpC and pAmpC, classical β-lactamases and ESBLs are sensitive to β-lactamase inhibitors [16, 30, 36].
One of the most dangerous groups of bacterial enzymes, drawing particular attention from microbiologists, epidemiologists, and clinicians, are carbapenemases. The genes encoding these enzymes in Gram-negative rods of the Enterobacteriaceae family (CPE – Carbapenemase-Producing Enterobacteriaceae) are located on mobile genetic elements such as plasmids, integrons, or transposons.
In Class A β-lactamases, plasmid-mediated Klebsiella pneumoniae carbapenemases (KPC) and chromosomally encoded enzymes such as NMCA, IMI, SME, and GES, which are inhibited by boronic acid, are of particular importance. The blaKPC gene, located on plasmids or transposons, often coexists with other resistance genes. KPC car-bapenemases are sensitive to β-lactamase inhibitors, allowing the effective use of new antibiotic combinations with inhibitors, such as ceftazidime-avibactam [25, 26, 44].
Class B includes metallo-β-lactamases (MBLs), which are inhibited by EDTA and dipicolinic acid. The genes encoding MBLs are primarily located in Class I integrons. As with blaKPC, the blaNDM gene often coexists with resistance genes to other antibiotic groups. Currently, there are no clinically available inhibitors that effectively block the activity of metallo-β-lactamases [23, 48].
Class D carbapenemases includes the so-called Carbapenem-Hydrolyzing Class D β-Lactamases (CHDLs), among which the most clinically important are OXA β-lactamases. In Enterobacteriaceae, the most significant enzyme is OXA-48. The blaOXA-48 genes are located on plasmids and typically do not coexist with other resistance genes. OXA-48 enzymes are highly active against penicillins, moderately active against broad-spectrum cephalosporins, and have low activity against carbapenems, except for ertapenem [36,44]. Moreover, these enzymes are insensitive to β-lactamase inhibitors and exhibit a high potential for mutation and expansion of their spectrum of activity [43].
Among OXA enzymes, those produced by Acinetobacter baumannii, such as OXA-23, OXA-40, and OXA-58, are particularly important as they significantly complicate the treatment of infections caused by this pathogen [21].
Resistance to β-lactam antibiotics can result from mutations in the target proteins, known as penicillin-binding proteins (PBP). Changes in these proteins lead to a reduced affinity of the antibiotic for the target site, resulting in resistance.
In Staphylococcus bacteria, the resistance mechanism is associated with the appearance of a new PBP, PBP2a (or PBP2’), encoded by the mecA gene (or less commonly mecC) [2,36]. These altered PBPs retain enzymatic activity but exhibit significantly reduced affinity for β-lactam antibiotics. As a result, methicillin-resistant strains that are resistant to all β-lactam antibiotics are selected. The following groups are distinguished: MRSA (Methicillin-Resistant Staphylococcus aureus) – methicillin-resistant strains, MRCNS (Methicillin-Resistant Coagulase-Negative Staphylococcus) – methicillin-resistant coagulase-negative staphylococci. On the other hand, methicillin-susceptible strains that are also sensitive to β-lactam antibiotics are denoted as: MSSA (Methicillin-Susceptible Staphylococcus aureus), MSCNS (Methicillin-Susceptible Coagulase-Negative Staphylococcus).
Similar resistance mechanisms are observed in Streptococcus pneumoniae, where modification of PBPs leads to reduced affinity for β-lactams and selection of strains resistant to these antibiotics.
In Gram-negative rods of the Haemophilus genus, resistance to β-lactams results mainly from the production of β-lactamases and modification of PBPs, which decrease the efficacy of β-lactam antibiotics.
These resistance mechanisms in these bacteria are particularly significant from both an epidemiological and clinical perspective, as they lead to difficulties in treating infections caused by these pathogens.
Apart from the broad group of β-lactam antibiotics, there are many other antimicrobial drugs for which microorganisms have developed various resistance mechanisms.
Resistance to fluoroquinolones can result from several mechanisms: modification of the target site, disruption of cell membrane permeability, active drug efflux, and enzymatic modification of the antibiotic. A key mechanism involves mutations in genes encoding DNA gyrase and topoisomerase IV, leading to reduced drug affinity for the molecular target. Permeability defects are associated with mutations in genes encoding outer membrane porin proteins, which limit the penetration of fluoroquinolones into the cell. These mutations can cause a decrease in the number of channels, their closure, or structural changes that hinder transport. Efflux pumps, composed of transport proteins, actively remove the drug from the cell, lowering its concentration in the cytoplasm and ensuring the cell’s survival. Enzymatic modification of fluoroquinolones involves the acetylation of the piperazine ring of ciprofloxacin by aminoglycoside acetyltransferase [35, 41].
Resistance to macrolides, lincosamides and streptogramins is often cross-resistant and can be caused by methylation of 23S rRNA in the ribosome (erm gene), which changes the binding site for the antibiotic. Additionally, resistance can be due to active transport of the drug out of the cell via efflux pumps (mefA gene in Streptococcus and msrA/msrB in Staphylococcus) or enzymatic inactivation (ere genes encoding staphylococcal esterases) [2, 4, 9].
Resistance to aminoglycosides is mainly related to the activity of enzymes modifying the antibiotic – AME (aminoglycoside-modifying enzymes), which include phosphotransferases (APH), acetyltransferases (AAC) and nucleotidyltransferases (ANT). Resistance can also result from modification of the target site in 16S rRNA of the 30S ribosomal subunit by methyltransferases, active drug efflux via pumps, and changes in porin proteins [15, 41].
The resistance mechanism to glycopeptides, such as vancomycin, involves the synthesis of modified precursors of the cell wall peptidoglycan. Instead of D-alanine-D-alanine, D-alanine-D-lactate or D-alanine-D-serine are produced, which have significantly lower affinity for vancomycin. In bacteria from the genus Enterococcus, resistance phenotypes such as VanA and VanB are most common. An increasing problem is the transfer of the vanA gene to Staphylococcus aureus, leading to the emergence of vancomycin-resistant strains (VISA/VRSA) [29, 41].
Due to the widespread use of trimethoprim-sulfamethoxazole, it is important to understand the mechanisms of resistance to this drug. These include reduced cell wall permeability, modification of target sites, and the presence of enzymes that degrade the drug [36].
Several definitions of microbial resistance are used in the medical literature. To standardize the terminology, experts from the ECDC (European Centre for Disease Prevention and Control) and CDC (Centers for Disease Control and Prevention) have established the following classifications:
MDR (Multidrug-Resistant): Resistance to at least one drug in three or more antibiotic classes.
XDR (Extensively Drug-Resistant): Resistance to all antibiotic classes except for two or fewer classes (the bacteria remain susceptible to only one or two drug classes).
PDR (Pan-Drug-Resistant): Resistance to all available antibiotics.
Correctly classifying a strain requires determining its susceptibility to a wide panel of antimicrobial agents to avoid misclassification resulting from selective reporting [10].
Multidrug resistance is one of the greatest challenges in modern medicine. A key mechanism responsible for this problem is the efflux pump system. These systems, built from proteins belonging to the SMR, MF, AMB, MATE, and RND families, actively remove toxic compounds, including antibiotics, chemotherapeutics, and detergents, from the bacterial cell interior.
Genes encoding efflux pumps can be located in both the chromosome and mobile elements, such as plasmids, integrons, and transposons, facilitating horizontal transfer of resistance between bacteria. Intensive research is currently underway on inhibitors of efflux pumps that could enhance the effectiveness of antimicrobial therapy [8].
Hospital infections, also known as healthcare-associated infections (HAI), are a significant problem in modern medicine. These infections occur during a patient’s stay in a healthcare facility and can lead to severe complications, such as sepsis, and even death [5]. According to the WHO, the average incidence of hospital infections is 8.7% [45].
The most common cause of these infections are multidrug-resistant pathogens. Infections may occur as a result of invasive procedures (such as urinary catheters, central venous catheters, mechanical ventilation, and surgical interventions), improper use of broad-spectrum antibiotics, and insufficient infection control measures.
Risk factors include the patient’s age, length of hospitalization, chronic diseases (such as diabetes, kidney failure, and lung diseases) and malnutrition (Fig. 3) [5]. In the prevention of hospital infections, key measures include the use of personal protective equipment, disinfection, and rational antibiotic therapy (Fig. 4) [5].

Risk Factors for the Development of Hospital Infections

Prevention Methods Effective in Preventing Hospital Infections
Staphylococcus aureus (Fig. 5) is one of the most common etiological factors of hospital-acquired infections. These infections primarily affect the skin, subcutaneous tissue, as well as causing bacteremia, pneumonia, and surgical site infections [18]. In dermatological populations, MRSA infections can affect up to 22% of patients [51]. These strains are characterized by high morbidity and mortality, making them a significant clinical threat [52]. Patients colonized with S. aureus are the main source of hospital-acquired infections. Persistent carriage of this microorganism occurs in 10–20% of the population, and temporary carriage can affect up to 50%. Approximately 25% of healthcare workers are carriers of S. aureus [28].
In vitro cultures of Staphylococcus aureus on Columbia Agar with 5% sheep blood (A) and a Gram-stained preparation of Staphylococcus aureus viewed under a light microscope (magnification x1000). Source: own elaboration.
Enterococcus are microorganisms naturally resistant to β-lactam antibiotics, low concentrations of aminoglycosides, tetracyclines, macrolides, and lincosamides, while acquired resistance to glycopeptides (GRE – glycopeptide-resistant Enterococcus) is common among hospital strains [9]. The emergence of vancomycin-resistant Enterococcus strains in the hospital environment has been primarily caused by the widespread use of cephalosporins, aminoglycosides, fluoroquinolones, and most notably, glycopeptides [20,46]. Enterococcus spread easily within the hospital environment between patients. This is often due to contaminated hands of healthcare staff and direct patient-to-patient contact. This leads primarily to patient and environmental colonization and poses a significant clinical and therapeutic challenge [6]. E. faecalis and E. faecium are etiological agents of various clinical forms of infections. Common infections include urinary tract infections, endocarditis, pressure ulcers, post-burn wound infections, peritonitis, cholangitis, intra-abdominal abscesses, bloodstream infections (bacteremia) and infections related to the maintenance of central venous catheters [11,20]. Patients at risk of VRE infections include those undergoing organ transplants, patients with hematologic malignancies, and those hospitalized in Intensive Care Units. E. faecium (15–80%) is most commonly found in the hospital environment, while E. faecalis is less common (5–10%). E. faecium accounts for a significant proportion of hospital infections caused by vancomycin-resistant enterococci (VRE) [11, 22, 46] (Fig. 6).
In vitro cultures of Enterococcus faecalis on Columbia Agar with 5% sheep blood (A) and a Gram-stained preparation of Enterococcus faecalis viewed under a light microscope (magnification x1000). Source: own elaboration.
Multidrug-resistant Gram-negative rods pose a significant threat to patient health and life in healthcare settings, particularly in Intensive Care Units (ICU). Infections caused by Gram-negative rods represent a major therapeutic challenge, especially for ICU patients, due to the high prevalence of multidrug-resistant bacterial strains [29]. One of the most pressing issues in hospital infections are those caused by strains producing extended-spectrum β-lactamases (ESBL), such as Klebsiella pneumoniae, Escherichia coli and Proteus mirabilis. Another worrying issue is the high resistance level to third-generation cephalosporins (AmpC β-lactamases) among Enterobacter species, as well as multidrug resistance in Pseudomonas aeruginosa and Acinetobacter baumannii strains. Additionally, the emergence of carbapenem-resistant strains (KPC, MBL) has become a significant global public health threat [44]. Particularly alarming is the rise of pan-drug resistance (PDR) in Gram-negative rods. The most dangerous pathogens exhibiting rapidly increasing drug resistance include Klebsiella, Enterobacter, Pseudomonas aeruginosa, and Acine-tobacter baumannii [27].
Escherichia coli (Fig. 7) is the leading cause of urinary tract infections [47]. It also causes intra-abdominal infections, pneumonia and bacteremia. E. coli was the dominant pathogen in urinary tract infections in U.S. hospitals (25–26%) and accounted for 6.5%-10% of surgical site or wound infections. Klebsiella pneumoniae is the second most common pathogen in hospital-acquired urinary tract infections after E. coli. It is also responsible for bloodstream infections and hospital-acquired respiratory infections. Due to the severe nature of infections caused by E. coli and K. pneumoniae, which can sometimes be life-threatening (especially in cases of sepsis, meningitis, and pneumonia), proper microbiological diagnostics are crucial. Hospital infections involving these two species are often caused by strains resistant to most β-lactam antibiotics, with mechanisms such as ESBL and MBL, and sometimes also resistance to other classes of antimicrobial agents (multidrug-resistant strains). Epidemic infections caused by E. coli and K. pneumoniae most often affect ICU patients [3].
In vitro cultures of Escherichia coli on Columbia Agar with 5% sheep blood (A) and a Gramstained preparation of Escherichia coli viewed under a light microscope (magnification x1000). Source: own elaboration.
Acinetobacter baumannii and Pseudomonas aeruginosa are microorganisms on the global priority list of antibiotic-resistant bacteria identified by the World Health Organization (WHO) [50]. These multidrug-resistant (MDR) bacteria have the potential to cause widespread infections and epidemic outbreaks [52]. Acinetobacter baumannii (Fig. 8) is responsible for many severe infections. It is a causative agent of bacteremia, pneumonia (especially ventilator-associated pneumonia), urinary tract infections, and meningitis. Infections caused by this pathogen are reported worldwide, and their incidence continues to rise [40].

In vitro cultures of Acinetobacter baumannii on Columbia Agar with 5% sheep blood (A) and a Gram-stained preparation of Acinetobacter baumannii viewed under a light microscope (magnification x1000). Source: own elaboration.
Pseudomonas aeruginosa (Fig. 9) is an opportunistic pathogen found in healthcare settings and is one of the leading causes of hospital-acquired pneumonia with high mortality rates. Additionally, it causes bacteremia and septic shock in immunocompromised patients [39]. The eradication of Pseudomonas aeruginosa is becoming increasingly difficult due to its remarkable ability to develop resistance to antibiotics. Recent descriptions of adaptive resistance mechanisms in P. aeruginosa include resistance through biofilm formation and the ability to form persister cells resistant to many new drugs. This mechanism is responsible for resistance and the recurrence of infections [33]. According to data, P. aeruginosa was the third most common cause of hospital-acquired urinary tract infections in the USA and the fifth in Europe [27]. Hospital infections caused by opportunistic non-fermenting rods, such as A. baumannii and P. aeruginosa, present an escalating challenge for clinicians due to the continuously rising antibiotic resistance [52].

In vitro cultures of Pseudomonas aeruginosa on Columbia Agar with 5% sheep blood (A) and a Gram-stained preparation of Pseudomonas aeruginosa viewed under a light microscope (magnification x1000). Source: own elaboration.
The use of antibiotics and the growing resistance of microorganisms are phenomena closely related, requiring a comprehensive approach to control. The assessment of antibiotic consumption can be conducted at the level of the patient, department, or the entire medical facility [41]. To effectively limit the spread of antibiotic resistance, it is necessary to implement educational, restrictive, and organizational measures, including ensuring effective oversight of antibiotic use [15]. Responsible antibiotic therapy, based on rational reduction, not only reduces treatment costs but also limits the selection and development of resistance in bacteria that may colonize patients or cause infections in hospitals [3].
Preventing hospital-acquired infections is primarily about limiting transmission, both exogenous and endogenous. Exogenous transmission occurs through patient-to-patient contact, contact between patients and medical umer, as well as environmental contamination in healthcare settings. Key elements of prevention include proper hand hygiene, patient isolation, the use of personal protective equipment, avoiding unnecessary invasive procedures (e.g., catheterization), and removing catheters as soon as they are no longer needed. Endogenous transmission, on the other hand, results from improper antibiotic therapy, especially the overuse of broad-spectrum antibiotics. This can lead to the transfer of pathogens from one part of the body to another, causing infections. Patients who are malnourished or immunocompromised are particularly at risk.
To effectively counteract the rise of microbial resistance, adherence to proper antibiotic therapy guidelines is essential, including the correct choice of medication, proper dosage, and the duration of treatment [5]. Unfortunately, the number of infections caused by antibiotic-resistant microorganisms continues to rise. Microbial resistance is a global health problem and one of the most serious public health threats. In a situation where the development of new antibiotics is becoming increasingly rare, protecting available medications through the rational use of antibiotics is crucial.
B-lactam antibiotics, including carbapenems, often referred to as „last-resort drugs,” hold a special place in the treatment of bacterial infections. Unfortunately, the emergence of new resistance mechanisms to these drugs raises serious concerns and poses a real threat, particularly in patients infected with multidrug-resistant pathogens [17,24].
Many hospital-acquired infections can be effectively prevented through the consistent implementation of guidelines developed by public health institutions such as the Centers for Disease Control and Prevention (CDC). Infection Control Teams (ICTs) play a key role in monitoring and limiting infections by actively registering cases. This surveillance includes assessing the clinical characteristics of infections, identifying causative agents, and analyzing the resistance patterns of isolated microorganisms.
One of the fundamental duties of ICTs is to monitor and document infections caused by multidrug-resistant microorganisms, known as „alert pathogens.” Systematic monitoring, combined with rational antibiotic use, is a crucial tool in the fight against rising antimicrobial resistance and is essential for protecting the future effectiveness of antimicrobial therapies.